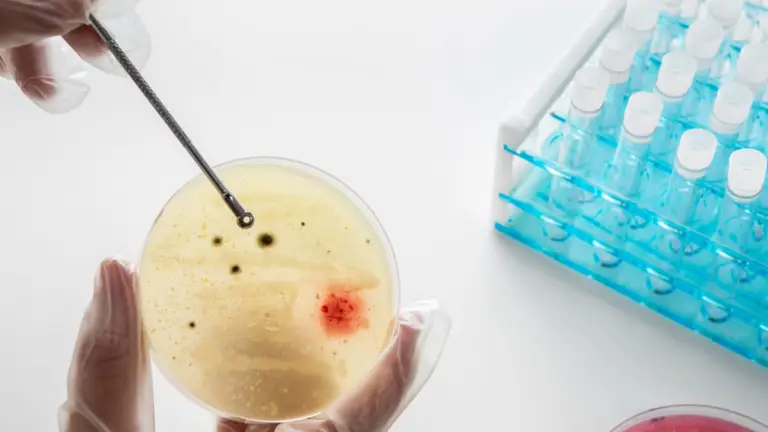

Investigadores de la Universidad de Bergen (Noruega), QIMR Berghofer y la Universidad Flinders (Australia) han logrado un avance significativo en la lucha contra las infecciones bacterianas. Descubrieron que al añadir nanopartículas de puntos cuánticos de carbono y cobalto a una solución de vinagre (ácido acético diluido), se crea un tratamiento antimicrobiano poderoso.
Los biólogos moleculares, el Dr. Adam Truskewycz y el profesor Nils Halberg, lideraron el estudio, cuyos hallazgos se publicaron en la revista internacional ACS Nano.
¿Cómo funciona el "súper-vinagre"?
El secreto está en la combinación: el ambiente ácido del vinagre hace que las células bacterianas se hinchen y, por lo tanto, absorban mejor el tratamiento de nanopartículas. Una vez dentro o en la superficie de la bacteria, las nanopartículas de carbono y cobalto la atacan, provocando su ruptura y eliminándola.
Esta mezcla fue probada con éxito contra patógenos resistentes a los medicamentos, como el Staphylococcus aureus, la Escherichia coli (E. coli) y el Enterococcus faecalis. Lo más importante es que este método demostró no ser tóxico para las células humanas. De hecho, eliminó infecciones bacterianas en heridas de ratones sin afectar su curación.
Una nueva esperanza contra la resistencia
Este descubrimiento es una contribución crucial para combatir la resistencia a los antimicrobianos, un problema de salud global que se asocia con millones de muertes al año.
El profesor Halberg enfatiza que la clave está en los tratamientos combinados, como el destacado en este estudio, para aumentar la efectividad de los tratamientos tradicionales.
Visita nuestra sección Variedades
Mantente informado en nuestros canales de WhatsApp, Telegram y YouTube